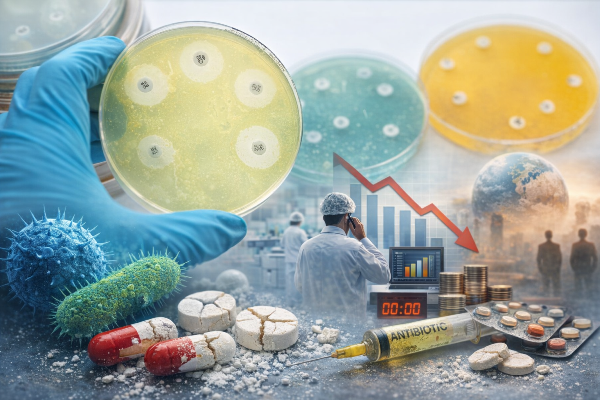

Antimikrobiyal direnç (AMR), modern tıbbın en büyük tehditlerinden biri haline geldi. 2026 Benchmark raporu, ilaç endüstrisinin bu tehdide karşı verdiği yanıtın yetersiz olduğunu açıkça gösteriyor. Editör olarak vurgulamak isterim ki, bu tablo yalnızca ilaç geliştirme süreçlerini değil, aynı zamanda küresel halk sağlığı politikalarını da yeniden düşünmemizi gerektiriyor.
2026 Antimicrobial Resistance Benchmark
Access to Medicine Foundation tarafından yayımlanan 2026 Antimikrobiyal Direnç Benchmark Raporu, 25 ilaç şirketinin AMR ile mücadele kapsamındaki performansını değerlendirdi. Rapor, ilaç endüstrisinin genel olarak dirençli enfeksiyonlara karşı yetersiz kaldığını ve mevcut çabaların küresel tehdit seviyesinin gerisinde olduğunu ortaya koydu.
Öne Çıkan Bulgular
- GSK, büyük Ar-Ge odaklı şirketler arasında liderliğini korurken, Pfizer önceki lider konumunu kaybetti.
- Shionogi, performansını en çok artıran şirket oldu.
- Aurobindo, jenerik ilaç üreticileri arasında en yüksek puanı aldı.
- Küçük ve orta ölçekli işletmeler (KOBİ’ler), yüksek öncelikli patojenlere yönelik yenilikçi projelerle öne çıktı.
Endişe Verici Gelişmeler
- Antimikrobiyal Ar-Ge faaliyetlerinde düşüş gözlemlendi; özellikle çocuklar için ilaç geliştirme yetersiz kaldı.
- Mevcut ilaçların erişimi, düşük ve orta gelirli ülkelerde hâlâ sınırlı.
- Sektör genelinde ilerleme yavaşladı, hiçbir şirket potansiyelinin tamamına ulaşamadı.
Enfeksiyonlara Karşı Umut Veren Projeler
Raporda, idrar yolu, karın içi ve solunum yolu enfeksiyonlarına karşı geliştirilen bazı geç aşama projelerin, düşük gelirli ülkelerde erişilebilir hale gelmesi durumunda binlerce hayat kurtarabileceği vurgulandı.
CEO Görüşü
Jayasree K. Iyer, “Süper mikroplara karşı mücadelede dengeyi insanlığın lehine çevirmek için daha kapsamlı ve koordineli adımlar gerekiyor” dedi.
Sektöre Mesaj
Rapor, şirketlere özel “İyileştirme Fırsatları” sunarak, Ar-Ge, üretim ve erişim alanlarında daha etkili stratejiler geliştirmeleri gerektiğini belirtiyor.